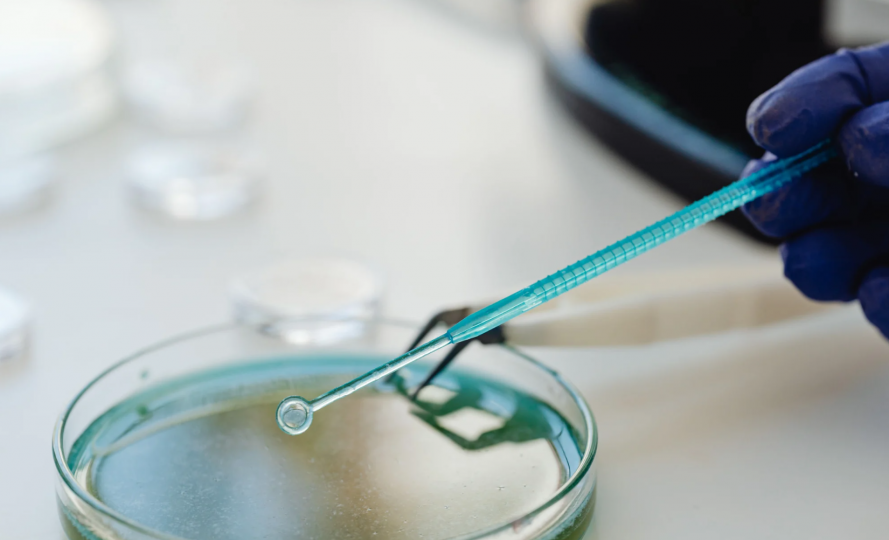

Certificación ISO 9001:2015/NMX-CC-9001-IMNC-2015
N° 000414SGC9001
Alcance: Análisis de Estudios microbiológicos para la industria controlada
ContÁctanos

El analisis en el agua se pueden encontrar una gran variedad de microorganismos, los cuales afectan en mayor o menor medida a la calidad sanitaria del agua.

La calidad microbiológica que este posee, depende del cumplimiento de la normatividad sanitaria vigente, de las condiciones y medida que se tengan durante la producción, almacenamiento, distribución y preparación de los alimentos.
En laboratorios AmbientekLab del Norte se ofrece una amplia gama de pruebas microbiológicas entorno a la industria, basándose en lineamientos nacionales e internacionales, así como requeridos por las autoridades sanitarias.
El laboratorio Ambienteklab del Norte S. de R.L. de C.V., se compromete con el cumplimiento de los estándares de la ISO 9001 en sus versiones vigentes a través de un sistema de gestión de la calidad eficaz para realizar el Análisis de Estudios Microbiológicos para la Industria Controlada.
Estamos comprometidos través de la mejora continua de nuestro sistema de gestión de la calidad y de sus procesos para satisfacer las necesidades de nuestros clientes y otras partes interesadas mediante el cumplimiento de las normatividades que apliquen, el apego a las buenas prácticas de laboratorio, la competencia técnica del personal, confidencialidad e imparcialidad, manteniendo siempre la moral y la ética profesional.
FOR-MPGC-00/C Rev. 002 Próxima revisión 2028/10/02